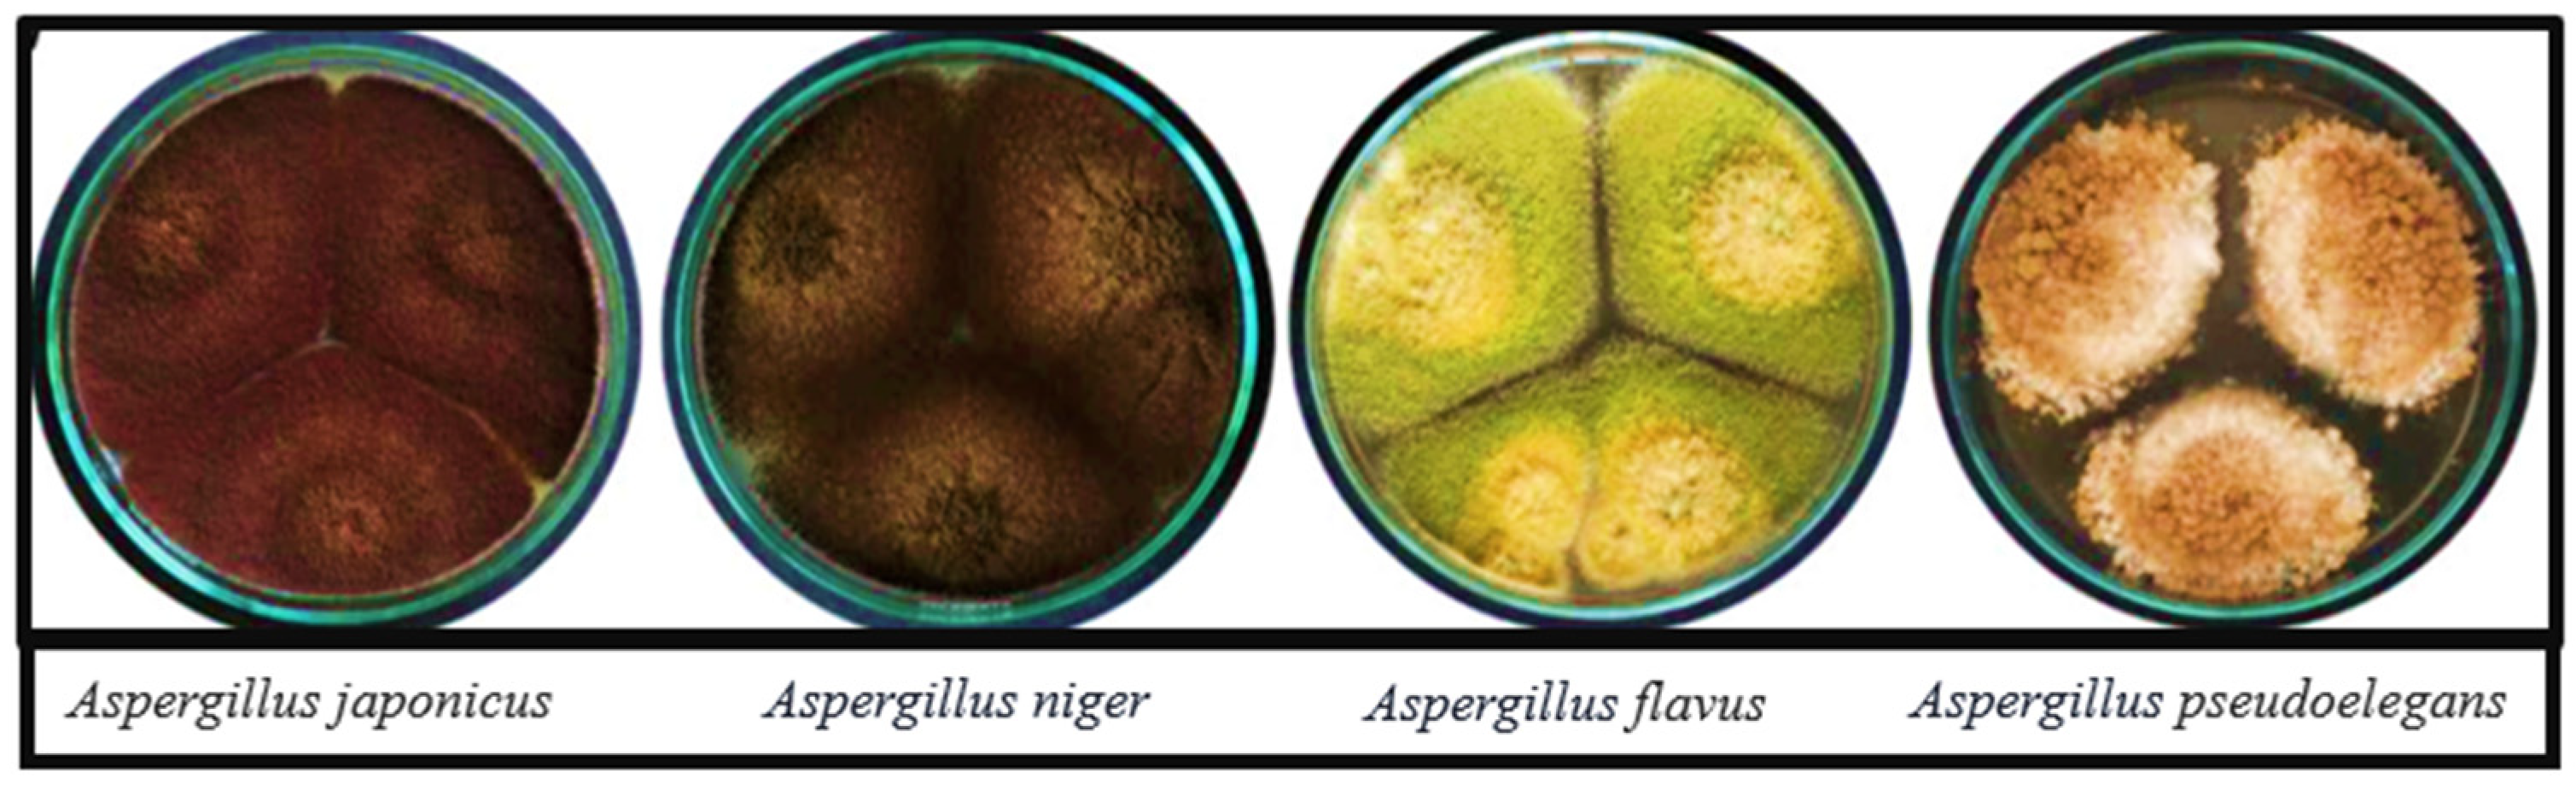
Jfb 16 00129 g001

Role of Endophytic Fungi in the Biosynthesis of Metal Nanoparticles and Their Potential as Nanomedicines
Abstract
1. Introduction
2. Overview of Fungal Endophytes
3. Synthesis of Metal Nanoparticles by Endophytic Fungi
4. Characterisation Techniques
5. Biomedical Applications
5.1. Antibacterial Activity
5.2. Antifungal Activity
5.3. Antiviral Activity
5.4. Anticancer Activity
5.5. MNPs as Drug Delivery Agents
6. Recommendations and Future Perspectives
7. Conclusions
Author Contributions
Funding
Institutional Review Board Statement
Informed Consent Statement
Data Availability Statement
Conflicts of Interest
References
- Baig, N.; Kammakakam, I.; Falath, W. Nanomaterials: A review of synthesis methods, properties, recent progress, and challenges. Mater. Adv. 2021, 2, 1821–1871. [Google Scholar]
- Rao, A.; Roy, S.; Jain, V.; Pillai, P.P. Nanoparticle self-assembly: From design principles to complex matter to functional materials. ACS Appl. Mater. Interfaces 2022, 15, 25248–25274. [Google Scholar] [CrossRef]
- Malik, S.; Muhammad, K.; Waheed, Y. Nanotechnology: A revolution in modern industry. Molecules 2023, 28, 661. [Google Scholar] [CrossRef]
- Gupta, D.; Thakur, A.; Gupta, T.K. Green and sustainable synthesis of nanomaterials: Recent advancements and limitations. Environ. Res. 2023, 231, 116316. [Google Scholar] [CrossRef]
- Ahmed, A.; Usman, M.; Ji, Z.; Rafiq, M.; Yu, B.; Shen, Y.; Cong, H. Nature-inspired biogenic synthesis of silver nanoparticles for antibacterial applications. Mater. Today Chem. 2023, 27, 101339. [Google Scholar]
- Zhang, Y.-X.; Wang, Y.-H. Nonlinear optical properties of metal nanoparticles: A review. RSC Adv. 2017, 7, 45129–45144. [Google Scholar] [CrossRef]
- Ali, A.; Shah, T.; Ullah, R.; Zhou, P.; Guo, M.; Ovais, M.; Tan, Z.; Rui, Y. Review on recent progress in magnetic nanoparticles: Synthesis, characterization, and diverse applications. Front. Chem. 2021, 9, 629054. [Google Scholar]
- Hassan, H.; Sharma, P.; Hasan, M.R.; Singh, S.; Thakur, D.; Narang, J. Gold nanomaterials–The golden approach from synthesis to applications. Mater. Sci. Energy Technol. 2022, 5, 375–390. [Google Scholar] [CrossRef]
- Sawalha, H.; Ahmad, S.A.; Shaharuddin, N.A.; Sanusi, R.; Azzeme, A.M.; Naganthran, A.; De Silva, C.; Abiri, R. Antibacterial activity of green silver nanoparticles on the in vitro pathogen infected Eucalyptus pellita plant. Plant Cell Tissue Organ Cult. 2024, 156, 73. [Google Scholar] [CrossRef]
- Khan, R.; Haider, S.; Abd Razak, S.I.; Haider, A.; Khan, M.U.A.; Wahit, M.U.; Bukhari, N.; Ahmad, A. Recent advances in renewable polymer/metal oxide systems used for tissue engineering. Renew. Polym. Polym.-Met. Oxide Compos. 2022, 13, 395–445. [Google Scholar] [CrossRef]
- Lu, H.-T.; Huang, G.-Y.; Chang, W.-J.; Lu, T.-W.; Huang, T.-W.; Ho, M.-H.; Mi, F.-L. Modification of chitosan nanofibers with CuS and fucoidan for antibacterial and bone tissue engineering applications. Carbohydr. Polym. 2022, 281, 119035. [Google Scholar] [CrossRef]
- Ahmadian, Z.; Gheybi, H.; Adeli, M. Efficient wound healing by antibacterial property: Advances and trends of hydrogels, hydrogel-metal NP composites and photothermal therapy platforms. J. Drug Deliv. Sci. Technol. 2022, 73, 103458. [Google Scholar] [CrossRef]
- Ismail, E.; Mabrouk, M.; Salem, Z.A.; AbuBakr, N.; Beherei, H. Evaluation of innovative polyvinyl alcohol/alginate/green palladium nanoparticles composite scaffolds: Effect on differentiated human dental pulp stem cells into osteoblasts. J. Mech. Behav. Biomed. Mater. 2023, 140, 105700. [Google Scholar] [CrossRef]
- Thangadurai, D.; Islam, S.; Sangeetha, J.; Cruz-Martins, N. Biogenic Nanomaterials: Structural Properties and Functional Applications; CRC Press: Boca Raton, FL, USA, 2022. [Google Scholar]
- Tiwari, M.S.; Patil, P.D.; Deshmukh, G.P. Antimicrobial Magnetic Nanoparticles: A Potential Antibiotic Agent in the Era of Multi-Drug Resistance. In Advanced Antimicrobial Materials and Applications; Springer: Berlin/Heidelberg, Germany, 2020; pp. 193–224. [Google Scholar]
- Hachem, K.; Ansari, M.J.; Saleh, R.O.; Kzar, H.H.; Al-Gazally, M.E.; Altimari, U.S.; Hussein, S.A.; Mohammed, H.T.; Hammid, A.T.; Kianfar, E. Methods of chemical synthesis in the synthesis of nanomaterial and nanoparticles by the chemical deposition method: A review. Bionanoscience 2022, 12, 1032–1057. [Google Scholar] [CrossRef]
- Kumari, S.; Raturi, S.; Kulshrestha, S.; Chauhan, K.; Dhingra, S.; András, K.; Thu, K.; Khargotra, R.; Singh, T. A comprehensive review on various techniques used for synthesizing nanoparticles. J. Mater. Res. Technol. 2023, 27, 1739–1763. [Google Scholar] [CrossRef]
- Yaqoob, A.A.; Umar, K.; Ibrahim, M.N.M. Silver nanoparticles: Various methods of synthesis, size affecting factors and their potential applications—A review. Appl. Nanosci. 2020, 10, 1369–1378. [Google Scholar] [CrossRef]
- Mazari, S.A.; Ali, E.; Abro, R.; Khan, F.S.A.; Ahmed, I.; Ahmed, M.; Nizamuddin, S.; Siddiqui, T.H.; Hossain, N.; Mubarak, N.M. Nanomaterials: Applications, waste-handling, environmental toxicities, and future challenges—A review. J. Environ. Chem. Eng. 2021, 9, 105028. [Google Scholar] [CrossRef]
- Naik, B.S. Biosynthesis of silver nanoparticles from endophytic fungi and their role in plant disease management. In Microbial Endophytes; CRC press: Boca Raton, FL, USA, 2020; pp. 307–321. [Google Scholar]
- Uzair, B.; Liaqat, A.; Iqbal, H.; Menaa, B.; Razzaq, A.; Thiripuranathar, G.; Fatima Rana, N.; Menaa, F. Green and cost-effective synthesis of metallic nanoparticles by algae: Safe methods for translational medicine. Bioengineering 2020, 7, 129. [Google Scholar] [CrossRef]
- Khandel, P.; Yadaw, R.K.; Soni, D.K.; Kanwar, L.; Shahi, S.K. Biogenesis of metal nanoparticles and their pharmacological applications: Present status and application prospects. J. Nanostruct. Chem. 2018, 8, 217–254. [Google Scholar] [CrossRef]
- Gong, D.; Sun, L.; Li, X.; Zhang, W.; Zhang, D.; Cai, J. Micro/nanofabrication, assembly, and actuation based on microorganisms: Recent advances and perspectives. Small Struct. 2023, 4, 2200356. [Google Scholar] [CrossRef]
- Meena, M.; Swapnil, P.; Yadav, G.; Sonigra, P. Role of fungi in bio-production of nanomaterials at megascale. In Fungi Bio-prospects in Sustainable Agriculture, Environment and Nano-Technology; Elsevier: Amsterdam, The Netherlands, 2021; pp. 453–474. [Google Scholar]
- Kitching, M.; Ramani, M.; Marsili, E. Fungal biosynthesis of gold nanoparticles: Mechanism and scale up. Microb. Biotechnol. 2015, 8, 904–917. [Google Scholar]
- Schulz, B.; Boyle, C. The endophytic continuum. Mycol. Res. 2005, 109, 661–686. [Google Scholar]
- Bhunjun, C.S.; Phukhamsakda, C.; Hyde, K.D.; McKenzie, E.H.C.; Saxena, R.K.; Li, Q. Do all fungi have ancestors with endophytic lifestyles? Fungal Divers. 2024, 125, 73–98. [Google Scholar]
- Singh, V.K.; Kumar, A. Secondary metabolites from endophytic fungi: Production, methods of analysis, and diverse pharmaceutical potential. Symbiosis 2023, 90, 111–125. [Google Scholar]
- Roychoudhury, A.; Sarkar, S.; Chakraborty, S. Fungal-mediated synthesis of gold and titanium nanoparticles and their application in agriculture. In Myconanotechnology and Application of Nanoparticles in Biology; Elsevier: Amsterdam, The Netherlands, 2023; pp. 79–92. [Google Scholar]
- Alqarni, L.S.; Alghamdi, M.D.; Alshahrani, A.A.; Nassar, A.M. Green nanotechnology: Recent research on bioresource-based nanoparticle synthesis and applications. J. Chem. 2022, 2022, 4030999. [Google Scholar] [CrossRef]
- Perez, L.I.; Gundel, P.E.; Zabalgogeazcoa, I.; Omacini, M. An ecological framework for understanding the roles of Epichloe endophytes on plant defenses against fungal diseases. Fungal Biol. Rev. 2020, 34, 115–125. [Google Scholar]
- Le Cocq, K.; Gurr, S.J.; Hirsch, P.R.; Mauchline, T.H. Exploitation of endophytes for sustainable agricultural intensification. Mol. Plant Pathol. 2017, 18, 469–473. [Google Scholar]
- Grabka, R.; d’Entremont, T.W.; Adams, S.J.; Walker, A.K.; Tanney, J.B.; Abbasi, P.A.; Ali, S. Fungal endophytes and their role in agricultural plant protection against pests and pathogens. Plants 2022, 11, 384. [Google Scholar] [CrossRef]
- Chutulo, E.C.; Chalannavar, R.K. Endophytic mycoflora and their bioactive compounds from Azadirachta indica: A comprehensive review. J. Fungi 2018, 4, 42. [Google Scholar] [CrossRef]
- Durand, A.; Leglize, P.; Benizri, E. Are endophytes essential partners for plants and what are the prospects for metal phytoremediation? Plant Soil 2021, 460, 1–30. [Google Scholar] [CrossRef]
- Riva, V.; Mapelli, F.; Bagnasco, A.; Mengoni, A.; Borin, S. A meta-analysis approach to defining the culturable core of plant endophytic bacterial communities. Appl. Environ. Microbiol. 2022, 88, e02537-21. [Google Scholar]
- Atallah, O.O.; Mazrou, Y.S.A.; Atia, M.M.; Nehela, Y.; Abdelrhim, A.S.; Nader, M.M. Polyphasic characterization of four Aspergillus species as potential biocontrol agents for white mold disease of bean. J. Fungi 2022, 8, 626. [Google Scholar] [CrossRef] [PubMed]
- Martins, F.; Mina, D.; Pereira, J.A.; Baptista, P. Endophytic fungal community structure in olive orchards with high and low incidence of olive anthracnose. Sci. Rep. 2021, 11, 689. [Google Scholar] [CrossRef]
- Aghdam, S.A.; Brown, A.M.V. Deep learning approaches for natural product discovery from plant endophytic microbiomes. Environ. Microbiome 2021, 16, 6. [Google Scholar]
- Eo, J.-K.; Choi, J.-W.; Eom, A.-H. Diversity, Distribution, and Host Plant of Endophytic Fungi: A Focus on Korea. Mycobiology 2022, 50, 399–407. [Google Scholar]
- Liu-Xu, L.; Vicedo, B.; García-Agustín, P.; Llorens, E. Advances in endophytic fungi research: A data analysis of 25 years of achievements and challenges. J. Plant Interact. 2022, 17, 244–266. [Google Scholar]
- Voglmayr, H.; Fournier, J.; Jaklitsch, W.M. Two new classes of Ascomycota: Xylobotryomycetes and Candelariomycetes. Persoonia 2019, 42, 36–49. [Google Scholar]
- El-Hawary, S.S.; Moawad, A.S.; Bahr, H.S.; Abdelmohsen, U.R.; Mohammed, R. Natural product diversity from the endophytic fungi of the genus Aspergillus. RSC Adv. 2020, 10, 22058–22079. [Google Scholar]
- Sun, J.-Z.; Liu, X.-Z.; McKenzie, E.H.C.; Jeewon, R.; Liu, J.-K.; Zhang, X.-L.; Zhao, Q.; Hyde, K.D. Fungicolous fungi: Terminology, diversity, distribution, evolution, and species checklist. Fungal Divers. 2019, 95, 337–430. [Google Scholar]
- Qiao, M.; Zheng, H.; Lv, R.; Yu, Z. Neodactylariales, Neodactylariaceae (Dothideomycetes, Ascomycota): New order and family, with a new species from China. MycoKeys 2020, 73, 69. [Google Scholar]
- Rashmi, M.; Kushveer, J.S.; Sarma, V.V. A worldwide list of endophytic fungi with notes on ecology and diversity. Mycosphere 2019, 10, 798–1079. [Google Scholar]
- Singh, B.P. Advances in Endophytic Fungal Research: Present Status and Future Challenges; Springer: Berlin/Heidelberg, Germany, 2019. [Google Scholar]
- Yadav, A.N.; Kour, D.; Kaur, T.; Devi, R.; Yadav, A. Endophytic fungal communities and their biotechnological implications for agro-environmental sustainability. Folia Microbiol. 2022, 67, 203–232. [Google Scholar]
- Hashem, A.H.; Attia, M.S.; Kandil, E.K.; Fawzi, M.M.; Abdelrahman, A.S.; Khader, M.S.; Khodaira, M.A.; Emam, A.E.; Goma, M.A.; Abdelaziz, A.M. Bioactive compounds and biomedical applications of endophytic fungi: A recent review. Microb. Cell Fact. 2023, 22, 107. [Google Scholar] [PubMed]
- Gupta, A.; Meshram, V.; Gupta, M.; Goyal, S.; Qureshi, K.A.; Jaremko, M.; Shukla, K.K. Fungal endophytes: Microfactories of novel bioactive compounds with therapeutic interventions; A comprehensive review on the biotechnological developments in the field of fungal endophytic biology over the last decade. Biomolecules 2023, 13, 1038. [Google Scholar] [CrossRef]
- Mathur, P.; Saini, S.; Paul, E.; Sharma, C.; Mehtani, P. Endophytic fungi mediated synthesis of iron nanoparticles: Characterization and application in methylene blue decolorization. Curr. Res. Green Sustain. Chem. 2021, 4, 100053. [Google Scholar]
- Dinesh, B.; Monisha, N.; Shalini, H.R.; Prathap, G.K.; Poyya, J.; Shantaram, M.; Hampapura, J.S.; Karigar, C.S.; Joshi, C.G. Antibacterial activity of silver nanoparticles synthesized using endophytic fungus—Penicillium cinnamopurpureum. Spectrosc. Lett. 2022, 55, 20–34. [Google Scholar]
- Gond, S.K.; Mishra, A.; Verma, S.K.; Sharma, V.K.; Kharwar, R.N. Synthesis and characterization of antimicrobial silver nanoparticles by an endophytic fungus isolated from Nyctanthes arbor-tristis. Proc. Natl. Acad. Sci. India Sect. B Biol. Sci. 2020, 90, 641–645. [Google Scholar]
- Bagur, H.; Medidi, R.S.; Somu, P.; Choudhury, P.W.J.; Karua, C.S.; Guttula, P.K.; Melappa, G.; Poojari, C.C. Endophyte fungal isolate mediated biogenic synthesis and evaluation of biomedical applications of silver nanoparticles. Mater. Technol. 2022, 37, 167–178. [Google Scholar]
- Ranjani, S.; Shariq Ahmed, M.; MubarakAli, D.; Ramachandran, C.; Senthil Kumar, N.; Hemalatha, S. Toxicity assessment of silver nanoparticles synthesized using endophytic fungi against nosacomial infection. Inorg. Nano-Met. Chem. 2020, 51, 1080–1085. [Google Scholar]
- Ganesan, V.; Hariram, M.; Vivekanandhan, S.; Muthuramkumar, S. Periconium sp. (endophytic fungi) extract mediated sol-gel synthesis of ZnO nanoparticles for antimicrobial and antioxidant applications. Mater. Sci. Semicond. Process. 2020, 105, 104739. [Google Scholar]
- Abd-Elsalam, K.A. Fungal Nanotechnology for Improving Farm Productivity and Sustainability: A Note from the Editor; Plant Pathology Research Institute, Agricultural Research Center: Giza, Egypt, 2023. [Google Scholar]
- Indiarto, R.; Indriana, L.P.A.; Andoyo, R.; Subroto, E.; Nurhadi, B. Bottom–up nanoparticle synthesis: A review of techniques, polyphenol-based core materials, and their properties. Eur. Food Res. Technol. 2022, 248, 1–24. [Google Scholar]
- Sawalha, H.; Abiri, R.; Sanusi, R.; Shaharuddin, N.A.; Noor, A.A.M.; Ab Shukor, N.A.; Abdul-Hamid, H.; Ahmad, S.A. Toward a better understanding of metal nanoparticles, a novel strategy from Eucalyptus plants. Plants 2021, 10, 929. [Google Scholar] [CrossRef] [PubMed]
- Salem, S.S.; Hammad, E.N.; Mohamed, A.A.; El-Dougdoug, W. A comprehensive review of nanomaterials: Types, synthesis, characterization, and applications. Biointerface Res. Appl. Chem 2022, 13, 41. [Google Scholar]
- Wu, K.; Su, D.; Liu, J.; Saha, R.; Wang, J.-P. Magnetic nanoparticles in nanomedicine: A review of recent advances. Nanotechnology 2019, 30, 502003. [Google Scholar]
- Srinivash, M.; Krishnamoorthi, R.; Mahalingam, P.U.; Malaikozhundan, B.; Bharathakumar, S.; Gurushankar, K.; Dhanapal, K.; Samy, K.K.; Perumal, A.B. Nanomedicine for drug resistant pathogens and COVID-19 using mushroom nanocomposite inspired with bacteriocin—A Review. Inorg. Chem. Commun. 2023, 152, 110682. [Google Scholar]
- Modi, C.; Modi, V.; Ray, S.; Nariya, P.; Gadhvi, V. A Review of Magnetic Nanoparticle’s in Targeted Drug Delivery. Pharma News. 2023. Available online: https://www.pharmatutor.org/articles/a-review-of-magnetic-nanoparticles-in-targeted-drug-delivery (accessed on 25 February 2025).
- Baki, A. Continuous Synthesis of Iron Oxide Nanoparticles for Biomedical Applications. Ph.D. Thesis, Universität Mainz, Mainz, Germany, 2022. [Google Scholar]
- Shen, B.; Sun, S. Chemical synthesis of magnetic nanoparticles for permanent magnet applications. Chem. Eur. J. 2020, 26, 6757–6766. [Google Scholar]
- Rana, A.; Yadav, K.; Jagadevan, S. A comprehensive review on green synthesis of nature-inspired metal nanoparticles: Mechanism, application and toxicity. J. Clean. Prod. 2020, 272, 122880. [Google Scholar]
- Ahmad, F.; Ashraf, N.; Ashraf, T.; Zhou, R.-B.; Yin, D.-C. Biological synthesis of metallic nanoparticles (MNPs) by plants and microbes: Their cellular uptake, biocompatibility, and biomedical applications. Appl. Microbiol. Biotechnol. 2019, 103, 2913–2935. [Google Scholar] [CrossRef]
- El-Seedi, H.R.; El-Shabasy, R.M.; Khalifa, S.A.M.; Saeed, A.; Shah, A.; Shah, R.; Iftikhar, F.J.; Abdel-Daim, M.M.; Omri, A.; Hajrahand, N.H. Metal nanoparticles fabricated by green chemistry using natural extracts: Biosynthesis, mechanisms, and applications. RSC Adv. 2019, 9, 24539–24559. [Google Scholar] [CrossRef]
- Shafey, A.M.E. Green synthesis of metal and metal oxide nanoparticles from plant leaf extracts and their applications: A review. Green Process. Synth. 2020, 9, 304–339. [Google Scholar] [CrossRef]
- Thatyana, M.; Dube, N.P.; Kemboi, D.; Manicum, A.-L.E.; Mokgalaka-Fleischmann, N.S.; Tembu, J.V. Advances in phytonanotechnology: A plant-mediated green synthesis of metal nanoparticles using phyllanthus plant extracts and their antimicrobial and anticancer applications. Nanomaterials 2023, 13, 2616. [Google Scholar] [CrossRef] [PubMed]
- Najmi, A.; Javed, S.A.; Al Bratty, M.; Alhazmi, H.A. Modern approaches in the discovery and development of plant-based natural products and their analogues as potential therapeutic agents. Molecules 2022, 27, 349. [Google Scholar] [CrossRef] [PubMed]
- Peralta-Videa, J.R.; Huang, Y.; Parsons, J.G.; Zhao, L.; Lopez-Moreno, L.; Hernandez-Viezcas, J.A.; Gardea-Torresdey, J.L. Plant-based green synthesis of metallic nanoparticles: Scientific curiosity or a realistic alternative to chemical synthesis? Nanotechnol. Environ. Eng. 2016, 1, 4. [Google Scholar] [CrossRef]
- Akinfenwa, A.O.; Abdul, N.S.; Docrat, F.T.; Marnewick, J.L.; Luckay, R.C.; Hussein, A.A. Cytotoxic effects of Phytomediated silver and gold nanoparticles synthesised from rooibos (Aspalathus linearis), and Aspalathin. Plants 2021, 10, 2460. [Google Scholar] [CrossRef]
- Kumar, B.; Smita, K.; Debut, A.; Cumbal, L. Andean Sacha Inchi (Plukenetia volubilis L.) leaf-mediated synthesis of Cu2O nanoparticles: A low-cost approach. Bioengineering 2020, 7, 54. [Google Scholar] [CrossRef]
- Niculescu, A.-G.; Chircov, C.; Grumezescu, A.M. Magnetite nanoparticles: Synthesis methods—A comparative review. Methods 2022, 199, 16–27. [Google Scholar] [CrossRef]
- Annamalai, J.; Ummalyma, S.B.; Pandey, A.; Bhaskar, T. Recent trends in microbial nanoparticle synthesis and potential application in environmental technology: A comprehensive review. Environ. Sci. Pollut. Res. Int. 2021, 28, 49362–49382. [Google Scholar] [CrossRef]
- Saravanan, M.; Vahidi, H.; Ansari, M. Bioengineered Silver Nanoparticles for Antimicrobial; Elsevier: Amsterdam, The Netherlands, 2023. [Google Scholar]
- Mohd Yusof, H.; Mohamad, R.; Zaidan, U.H.; Abdul Rahman, N.A. Microbial synthesis of zinc oxide nanoparticles and their potential application as an antimicrobial agent and a feed supplement in animal industry: A review. J. Anim. Sci. Biotechnol. 2019, 10, 57. [Google Scholar] [CrossRef]
- Singh, M.; Singh, D.; Rai, P.K.; Suyal, D.C.; Saurabh, S.; Soni, R.; Giri, K.; Yadav, A.N. Fungi in Remediation of Hazardous Wastes: Current Status and Future Outlook; Springer: Berlin/Heidelberg, Germany, 2021. [Google Scholar]
- Kumari, K.A.; Mangatayaru, K.G.; Reddy, G.B. Fungal and yeast-mediated biosynthesis of metal nanoparticles: Characterization and bio applications. In Fungal Cell Factories for Sustainable Nanomaterials Productions and Agricultural Applications; Elsevier: Amsterdam, The Netherlands, 2023; pp. 309–336. [Google Scholar]
- Le Wee, J.; Law, M.C.; Chan, Y.S.; Choy, S.Y.; Tiong, A.N.T. The potential of Fe-based magnetic nanomaterials for the agriculture sector. ChemistrySelect 2022, 7, e202104603. [Google Scholar]
- Devi, L.; Kushwaha, P.; Ansari, T.M.; Kumar, A.; Rao, A. Recent trends in biologically synthesized metal nanoparticles and their biomedical applications: A review. Biol. Trace Elem. Res. 2024, 202, 3383–3399. [Google Scholar] [CrossRef]
- Priyadarshini, E.; Priyadarshini, S.S.; Cousins, B.G.; Pradhan, N. Metal-Fungus interaction: Review on cellular processes underlying heavy metal detoxification and synthesis of metal nanoparticles. Chemosphere 2021, 274, 129976. [Google Scholar] [PubMed]
- Silva, L.P.; Bonatto, C.C.; Polez, V.L.P. Green Synthesis of Metal Nanoparticles by Fungi: Current Trends and Challenges; Springer: Berlin/Heidelberg, Germany, 2016. [Google Scholar]
- Madkour, L.H. Biogenic–biosynthesis metallic nanoparticles (MNPs) for pharmacological, biomedical and environmental nanobiotechnological applications. Chron. Pharm. Sci. J 2018, 2, 384–444. [Google Scholar]
- Ahmad, N.M.; Mohamed, A.H.; Zainal-Abidin, N.; Nawahwi, M.Z.; Azzeme, A.M. Effect of optimisation variable and the role of plant extract in the synthesis of nanoparticles using plant-mediated synthesis approaches. Inorg. Chem. Commun. 2024, 161, 111839. [Google Scholar] [CrossRef]
- Seetharaman, P.K.; Chandrasekaran, R.; Periakaruppan, R.; Gnanasekar, S.; Sivaperumal, S.; Abd-Elsalam, K.A.; Valis, M.; Kuca, K. Functional attributes of myco-synthesized silver nanoparticles from endophytic fungi: A new implication in biomedical applications. Biology 2021, 10, 473. [Google Scholar] [CrossRef]
- Dinesh, B.; Joshi, C.G. Biosynthesis of silver nanoparticle using endophytic fungus (Simpicillium lanosoniveum) isolated from Sargassum wightii and its biological activity. arXiv 2023. [Google Scholar] [CrossRef]
- Carrapiço, A.; Martins, M.R.; Caldeira, A.T.; Mirão, J.; Dias, L. Biosynthesis of metal and metal oxide nanoparticles using microbial cultures: Mechanisms, antimicrobial activity and applications to cultural heritage. Microorganisms 2023, 11, 378. [Google Scholar] [CrossRef]
- Wojaczyńska, E.; Steppeler, F.; Iwan, D.; Scherrmann, M.-C.; Marra, A. Synthesis and applications of carbohydrate-based organocatalysts. Molecules 2021, 26, 7291. [Google Scholar] [CrossRef]
- Ma, J.-L.; Yin, B.-C.; Wu, X.; Ye, B.-C. Simple and cost-effective glucose detection based on carbon nanodots supported on silver nanoparticles. Anal. Chem. 2017, 89, 1323–1328. [Google Scholar] [CrossRef]
- Guo, Y.; Sun, Q.; Wu, F.G.; Dai, Y.; Chen, X. Polyphenol-Containing nanoparticles: Synthesis, properties, and therapeutic delivery. Adv. Mater. 2021, 33, 2007356. [Google Scholar] [CrossRef]
- Cirillo, G.; Curcio, M.; Vittorio, O.; Iemma, F.; Restuccia, D.; Spizzirri, U.G.; Puoci, F.; Picci, N. Polyphenol conjugates and human health: A perspective review. Crit. Rev. Food Sci. Nutr. 2016, 56, 326–337. [Google Scholar] [CrossRef]
- Spiegel, M.; Andruniów, T.; Sroka, Z. Flavones’ and flavonols’ antiradical structure–activity relationship—A quantum chemical study. Antioxidants 2020, 9, 461. [Google Scholar] [CrossRef] [PubMed]
- Pedroso-Santana, S.; Fleitas-Salazar, N. The use of capping agents in the stabilization and functionalization of metallic nanoparticles for biomedical applications. Part. Part. Syst. Charact. 2023, 40, 2200146. [Google Scholar] [CrossRef]
- Bhambhani, S.; Kondhare, K.R.; Giri, A.P. Diversity in chemical structures and biological properties of plant alkaloids. Molecules 2021, 26, 3374. [Google Scholar] [CrossRef]
- Nobahar, A.; Carlier, J.D.; Miguel, M.G.; Costa, M.C. A review of plant metabolites with metal interaction capacity: A green approach for industrial applications. BioMetals 2021, 34, 761–793. [Google Scholar] [CrossRef]
- Mylkie, K.; Nowak, P.; Rybczynski, P.; Ziegler-Borowska, M. Polymer-coated magnetite nanoparticles for protein immobilization. Materials 2021, 14, 248. [Google Scholar] [CrossRef]
- Jeevanandam, J.; Kiew, S.F.; Boakye-Ansah, S.; Lau, S.Y.; Barhoum, A.; Danquah, M.K.; Rodrigues, J. Green approaches for the synthesis of metal and metal oxide nanoparticles using microbial and plant extracts. Nanoscale 2022, 14, 2534–2571. [Google Scholar] [CrossRef] [PubMed]
- Aboyewa, J.A.; Sibuyi, N.R.S.; Meyer, M.; Oguntibeju, O.O. Green synthesis of metallic nanoparticles using some selected medicinal plants from southern africa and their biological applications. Plants 2021, 10, 1929. [Google Scholar] [CrossRef]
- Philip, A.; Kumar, A.R. The performance enhancement of surface plasmon resonance optical sensors using nanomaterials: A review. Coord. Chem. Rev. 2022, 458, 214424. [Google Scholar] [CrossRef]
- Lv, S.; Du, Y.; Wu, F.; Cai, Y.; Zhou, T. Review on LSPR assisted photocatalysis: Effects of physical fields and opportunities in multifield decoupling. Nanoscale Adv. 2022, 4, 2608–2631. [Google Scholar] [CrossRef]
- Gentili, P.L.; Micheau, J.-C. Light and chemical oscillations: Review and perspectives. J. Photochem. Photobiol. C Photochem. Rev. 2020, 43, 100321. [Google Scholar] [CrossRef]
- Ujica, M.A.; Paltinean, G.A.; Mocanu, A.; Tomoaia-Cotisel, M. Silver and gold nanoparticles: Challenges and perspectives. Acad. Rom. Sci. Ann.-Ser. Biol. Sci 2020, 9, 97–139. [Google Scholar] [CrossRef]
- Soltani Nejad, M.; Samandari Najafabadi, N.; Aghighi, S.; Pakina, E.; Zargar, M. Evaluation of Phoma sp. biomass as an endophytic fungus for synthesis of extracellular gold nanoparticles with antibacterial and antifungal properties. Molecules 2022, 27, 1181. [Google Scholar] [CrossRef] [PubMed]
- Faraji, M.; Yamini, Y.; Salehi, N. Characterization of magnetic nanomaterials. In Magnetic Nanomaterials in Analytical Chemistry; Elsevier: Amsterdam, The Netherlands, 2021; pp. 39–60. [Google Scholar]
- Li, Y.; Yang, J.; Pan, Z.; Tong, W. Nanoscale pore structure and mechanical property analysis of coal: An insight combining AFM and SEM images. Fuel 2020, 260, 116352. [Google Scholar] [CrossRef]
- Gomathi, A.C.; Rajarathinam, S.R.X.; Sadiq, A.M.; Rajeshkumar, S. Anticancer activity of silver nanoparticles synthesized using aqueous fruit shell extract of Tamarindus indica on MCF-7 human breast cancer cell line. Int. J. Drug Deliv. Technol. 2020, 55, 101376. [Google Scholar] [CrossRef]
- Fattahi, M.; Nezafat, N.B.; Ţălu, Ş.; Solaymani, S.; Ghoranneviss, M.; Elahi, S.M.; Shafiekhani, A.; Rezaee, S. Topographic characterization of zirconia-based ceramics by atomic force microscopy: A case study on different laser irradiations. J. Alloys Compd. 2020, 831, 154763. [Google Scholar] [CrossRef]
- Franken, L.E.; Grünewald, K.; Boekema, E.J.; Stuart, M.C. A technical introduction to transmission electron microscopy for soft-matter: Imaging, possibilities, choices, and technical developments. Small 2020, 16, 1906198. [Google Scholar] [CrossRef]
- Flinn, B.T.; Radu, V.; Fay, M.W.; Tyler, A.J.; Pitcairn, J.; Cliffe, M.; Weare, B.L.; Stoppiello, C.; Mather, M.L.; Khlobystov, A. Nitrogen Vacancy Defects in Singe-Particle Nanodiamonds Sense Paramagnetic Transition Metal Spins in Nanoparticles on a Transmission Electron Microscopy Grid. Nanoscale Adv. 2023, 5, 6423–6434. [Google Scholar] [CrossRef]
- Mandemaker, L.D.; Meirer, F. Spectro-Microscopic Techniques for Studying Nanoplastics in the Environment and in Organisms. Angew. Chem. Int. Ed. Engl. 2023, 62, e202210494. [Google Scholar] [CrossRef]
- Netala, V.R.; Kotakadi, V.S.; Bobbu, P.; Gaddam, S.A.; Tartte, V. Endophytic fungal isolate mediated biosynthesis of silver nanoparticles and their free radical scavenging activity and anti microbial studies. 3 Biotech 2016, 6, 132. [Google Scholar]
- Mostafa, E.M.; Abdelgawad, M.A.; Musa, A.; Alotaibi, N.H.; Elkomy, M.H.; Ghoneim, M.M.; Badawy, M.S.E.M.; Taha, M.N.; Hassan, H.M.; Hamed, A.A. Chitosan silver and gold nanoparticle formation using endophytic fungi as powerful antimicrobial and anti-biofilm potentialities. Antibiotics 2022, 11, 668. [Google Scholar] [CrossRef]
- Munawer, U.; Raghavendra, V.B.; Ningaraju, S.; Krishna, K.L.; Ghosh, A.R.; Melappa, G.; Pugazhendhi, A. Biofabrication of gold nanoparticles mediated by the endophytic Cladosporium species: Photodegradation, in vitro anticancer activity and in vivo antitumor studies. Int. J. Pharm. 2020, 588, 119729. [Google Scholar] [CrossRef] [PubMed]
- Stiufiuc, G.F.; Stiufiuc, R.I. Magnetic Nanoparticles: Synthesis, Characterization, and Their Use in Biomedical Field. Appl. Sci. 2024, 14, 1623. [Google Scholar] [CrossRef]
- Farinha, P.; Coelho, J.M.P.; Reis, C.P.; Gaspar, M.M. A comprehensive updated review on magnetic nanoparticles in diagnostics. Nanomaterials 2021, 11, 3432. [Google Scholar] [CrossRef] [PubMed]
- Chaikittisilp, W.; Yamauchi, Y.; Ariga, K. Material evolution with nanotechnology, nanoarchitectonics, and materials informatics: What will be the next paradigm shift in nanoporous materials? Adv. Mater. 2022, 34, 2107212. [Google Scholar] [CrossRef]
- Cardoso, V.F.; Francesko, A.; Ribeiro, C.; Bañobre-López, M.; Martins, P.; Lanceros-Mendez, S. Advances in magnetic nanoparticles for biomedical applications. Adv. Healthc. Mater. 2018, 7, 1700845. [Google Scholar]
- Singh, D.K.; Kumar, J.; Sharma, V.K.; Verma, S.K.; Singh, A.; Kumari, P.; Kharwar, R.N. Mycosynthesis of bactericidal silver and polymorphic gold nanoparticles: Physicochemical variation effects and mechanism. Nanomedicine 2018, 13, 191–207. [Google Scholar]
- Gholami-Shabani, M.; Sotoodehnejadnematalahi, F.; Shams-Ghahfarokhi, M.; Eslamifar, A.; Razzaghi-Abyaneh, M. Physicochemical properties, anticancer and antimicrobial activities of metallic nanoparticles green synthesized by Aspergillus kambarensis. IET Nanobiotechnol. 2022, 16, 1. [Google Scholar] [CrossRef]
- Akther, T.; Mathipi, V.; Kumar, N.S.; Davoodbasha, M.; Srinivasan, H. Fungal-mediated synthesis of pharmaceutically active silver nanoparticles and anticancer property against A549 cells through apoptosis. Environ. Sci. Pollut. Res. Int. 2019, 26, 13649–13657. [Google Scholar]
- Abdel-Kareem, M.M.; Zohri, A.A. Extracellular mycosynthesis of gold nanoparticles using Trichoderma hamatum: Optimization, characterization and antimicrobial activity. Lett. Appl. Microbiol. 2018, 67, 465–475. [Google Scholar]
- Clarance, P.; Luvankar, B.; Sales, J.; Khusro, A.; Agastian, P.; Tack, J.C.; Al Khulaifi, M.M.; Al-Shwaiman, H.A.; Elgorban, A.M.; Syed, A. Green synthesis and characterization of gold nanoparticles using endophytic fungi Fusarium solani and its in-vitro anticancer and biomedical applications. Saudi J. Biol. Sci. 2020, 27, 706–712. [Google Scholar] [CrossRef]
- Kadam, V.V.; Ettiyappan, J.P.; Balakrishnan, R.M. Mechanistic insight into the endophytic fungus mediated synthesis of protein capped ZnO nanoparticles. Mater. Sci. Eng. B 2019, 243, 214–221. [Google Scholar]
- Gupta, P.; Rai, N.; Verma, A.; Saikia, D.; Singh, S.P.; Kumar, R.; Singh, S.K.; Kumar, D.; Gautam, V. Green-based approach to synthesize silver nanoparticles using the fungal endophyte Penicillium oxalicum and their antimicrobial, antioxidant, and in vitro anticancer potential. ACS Omega 2022, 7, 46653–46673. [Google Scholar]
- Govindappa, M.; Lavanya, M.; Aishwarya, P.; Pai, K.; Lunked, P.; Hemashekhar, B.; Arpitha, B.M.; Ramachandra, Y.L.; Raghavendra, V.B. Synthesis and characterization of endophytic fungi, Cladosporium perangustum mediated silver nanoparticles and their antioxidant, anticancer and nano-toxicological study. BioNanoScience 2020, 10, 928–941. [Google Scholar] [CrossRef]
- Hu, X.; Saravanakumar, K.; Jin, T.; Wang, M.H. Mycosynthesis, characterization, anticancer and antibacterial activity of silver nanoparticles from endophytic fungus Talaromyces purpureogenus. Int. J. Nanomed. 2019, 14, 3427–3438. [Google Scholar] [CrossRef]
- Gallo, G.; Schillaci, D. Bacterial metal nanoparticles to develop new weapons against bacterial biofilms and infections. Appl. Microbiol. Biotechnol. 2021, 105, 5357–5366. [Google Scholar] [CrossRef]
- Kaur, H.; Rauwel, P.; Rauwel, E. Antimicrobial nanoparticles: Synthesis, mechanism of actions. In Antimicrobial Activity of Nanoparticles; Elsevier: Amsterdam, The Netherlands, 2023; pp. 155–202. [Google Scholar]
- Chinemerem Nwobodo, D.; Ugwu, M.C.; Oliseloke Anie, C.; Al-Ouqaili, M.T.; Chinedu Ikem, J.; Victor Chigozie, U.; Saki, M. Antibiotic resistance: The challenges and some emerging strategies for tackling a global menace. J. Clin. Lab. Anal. 2022, 36, e24655. [Google Scholar] [CrossRef]
- Behzad, F.; Naghib, S.M.; Tabatabaei, S.N.; Zare, Y.; Rhee, K.Y. An overview of the plant-mediated green synthesis of noble metal nanoparticles for antibacterial applications. Ind. Eng. Chem. 2021, 94, 92–104. [Google Scholar] [CrossRef]
- Neethu, S.; Midhun, S.J.; Radhakrishnan, E.K.; Jyothis, M. Green synthesized silver nanoparticles by marine endophytic fungus Penicillium polonicum and its antibacterial efficacy against biofilm forming, multidrug-resistant Acinetobacter baumanii. Microb. Pathog. 2018, 116, 263–272. [Google Scholar] [CrossRef]
- Govindappa, M.; Hemashekhar, B.; Arthikala, M.K.; Rai, V.R.; Ramachandra, Y.L. Characterization, antibacterial, antioxidant, antidiabetic, anti-inflammatory and antityrosinase activity of green synthesized silver nanoparticles using Calophyllum tomentosum leaves extract. Results Phys. 2018, 9, 400–408. [Google Scholar] [CrossRef]
- Feroze, N.; Arshad, B.; Younas, M.; Afridi, M.I.; Saqib, S.; Ayaz, A. Fungal mediated synthesis of silver nanoparticles and evaluation of antibacterial activity. Microsc. Res. Tech. 2020, 83, 72–80. [Google Scholar]
- Jyoti, K.; Arora, D.; Fekete, G.; Lendvai, L.; Dogossy, G.; Singh, T. Antibacterial and anti-inflammatory activities of Cassia fistula fungal broth-capped silver nanoparticles. Mater. Technol. 2021, 36, 883–893. [Google Scholar]
- Halkai, K.R.; Mudda, J.A.; Shivanna, V.; Rathod, V.; Halkai, R.S. Evaluation of antibacterial efficacy of biosynthesized silver nanoparticles derived from fungi against endo-perio pathogens Porphyromonas gingivalis, Bacillus pumilus, and Enterococcus faecalis. J. Conserv. Dent. 2017, 20, 398. [Google Scholar]
- Gajbhiye, M.; Kesharwani, J.; Ingle, A.; Gade, A.; Rai, M. Fungus-mediated synthesis of silver nanoparticles and their activity against pathogenic fungi in combination with fluconazole. Nanomed. Nanotechnol. Biol. Med. 2009, 5, 382–386. [Google Scholar]
- Bai, G.-H.; Lin, S.-C.; Hsu, Y.-H.; Chen, S.-Y. The human virome: Viral metagenomics, relations with human diseases, and therapeutic applications. Viruses 2022, 14, 278. [Google Scholar] [CrossRef]
- Vijayakumar, P.S.; Prasad, B.L.V. Intracellular Biogenic Silver Nanoparticles for the Generation of Carbon Supported Antiviral and Sustained Bactericidal Agents; ACS Publications: Washington, WA, USA, 2009. [Google Scholar]
- Gaikwad, S.; Ingle, A.; Gade, A.; Rai, M.; Falanga, A.; Incoronato, N.; Russo, L.; Galdiero, S.; Galdiero, M. Antiviral activity of mycosynthesized silver nanoparticles against herpes simplex virus and human parainfluenza virus type 3. Int. J. Nanomed. 2013, 8, 4303–4314. [Google Scholar]
- Rani, N.; Saini, K. Biogenic Metal and Metal Oxides Nanoparticles as Anticancer Agent: A Review; IOP Publishin: Lausanne, Switzerland, 2022; Volume 1225, p. 012043. [Google Scholar]
- Al-Jameel, S.S.; Rehman, S.; Almessiere, M.A.; Khan, F.A.; Slimani, Y.; Al-Saleh, N.S.; Manikandan, A.; Al-Suhaimi, E.A.; Baykal, A. Anti-microbial and anti-cancer activities of Mn0. 5Zn0. 5DyxFe2-xO4 (x ≤ 0.1) nanoparticles. Artif. Cells Nanomed. Biotechnol. 2021, 49, 493–499. [Google Scholar] [CrossRef]
- Khateef, R.; Khadri, H.; Almatroudi, A.; Alsuhaibani, S.A.; Mobeen, S.A.; Khan, R.A. Potential in-vitro anti-breast cancer activity of green-synthesized silver nanoparticles preparation against human MCF-7 cell-lines. Asian Nucl. Saf. Netw. 2019, 10, 045012. [Google Scholar] [CrossRef]
- Baker, A.; Iram, S.; Syed, A.; Elgorban, A.M.; Al-Falih, A.M.; Bahkali, A.H.; Khan, M.S.; Kim, J. Potentially bioactive fungus mediated silver nanoparticles. Nanomaterials 2021, 11, 3227. [Google Scholar] [CrossRef]
- Taha, Z.K.; Hawar, S.N.; Sulaiman, G.M. Extracellular biosynthesis of silver nanoparticles from Penicillium italicum and its antioxidant, antimicrobial and cytotoxicity activities. Biotechnol. Lett. 2019, 41, 899–914. [Google Scholar]
- Chandrakala, V.; Aruna, V.; Angajala, G. Review on metal nanoparticles as nanocarriers: Current challenges and perspectives in drug delivery systems. Emergent Mater. 2022, 5, 1593–1615. [Google Scholar] [CrossRef]
- Saravanan, M.; Barabadi, H.; Vahidi, H. Green nanotechnology: Isolation of bioactive molecules and modified approach of biosynthesis. In Biogenic Nanoparticles for Cancer Theranostics; Elsevier: Amsterdam, The Netherlands, 2021. [Google Scholar] [CrossRef]
- Ahmad Siddiqui, E.; Ahmad, A.; Julius, A.; Syed, A.; Khan, S.; Kharat, M.; Pai, K.; Kadoo, N.; Gupta, V. Biosynthesis of anti-proliferative gold nanoparticles using endophytic Fusarium oxysporum strain isolated from neem (A. indica) leaves. Curr. Top. Med. Chem. 2016, 16, 2036–2042. [Google Scholar] [CrossRef] [PubMed]
- Parmar, S.; Sharma, V.K. Endophytic fungi mediated biofabrication of nanoparticles and their potential applications. In Microbial Endophytes; Elsevier: Amsterdam, The Netherlands, 2020; pp. 325–341. [Google Scholar]
- Sarkar, J.; Ray, S.; Chattopadhyay, D.; Laskar, A.; Acharya, K. Mycogenesis of gold nanoparticles using a phytopathogen Alternaria alternata. Bioprocess Biosyst. Eng. 2012, 35, 637–643. [Google Scholar] [PubMed]
- Kaushal, M. Role of microbes in plant protection using intersection of nanotechnology and biology. In Nanobiotechnology Applications in Plant Protection; Springer: Cham, Switzerland, 2018; pp. 111–135. [Google Scholar] [CrossRef]
- Dhanjal, D.S.; Mehra, P.; Bhardwaj, S.; Singh, R.; Sharma, P.; Nepovimova, E.; Chopra, C.; Kuca, K. Mycology-nanotechnology interface: Applications in medicine and cosmetology. Int. J. Nanomed. 2022, 17, 2505–2533. [Google Scholar] [CrossRef]
- Vangijzegem, T.; Stanicki, D.; Laurent, S. Magnetic iron oxide nanoparticles for drug delivery: Applications and characteristics. Expert Opin. Drug Deliv. 2019, 16, 69–78. [Google Scholar] [CrossRef]
- Nabavinia, M.; Beltran-Huarac, J. Recent progress in iron oxide nanoparticles as therapeutic magnetic agents for cancer treatment and tissue engineering. ACS Appl. Bio Mater. 2020, 3, 8172–8187. [Google Scholar] [CrossRef]

| Host Plant | Endophytic Fungi | MNPs | Size (nm) | Shape | Activity | References |
|---|---|---|---|---|---|---|
| Centella asiatica | Aspergillus versicolor | AgNPs | 3–40 | Spherical | Strong antimicrobial agent and effective free radical scavenging activity | [113] |
| Catharanthus roseus | Botryosphaeria rhodia | AgNPs | <20 | Spherical | Anticancer material against A549 cancer cell line | [122] |
| Trichoderma hamatum | AuNPs | 5–30 | Spherical, Pentagonal, and Hexagonal | Antimicrobial activity against bacillus subtilis, staphylococcus aureus, pseudomonas aeruginosa, and Serratia | [123] | |
| Chonemorpha fragrance | Fusarium solani | AuNPs | ~40 and 45 | Spindle | Anticancer agent | [124] |
| Nothapodytes foetida | Cochliobolus geniculatus | ZnO | 2–6 | Spherical | n/a | [125] |
| Tinospora cordifolia | AgNPs | 25–35 | Spherical | Antibacterial, antioxidant, and anti-inflammatory activity | [54] | |
| Amoora rohituka | Penicillium oxalicum | AgNPs | 13–23 | Spherical | Antiproliferative activity towards breast cancer cells | [126] |
| Dendrophthoe falcata | Cladosporium perangustum | AgNPs | 30–40 | Spherical | Anticancer activity against MCF-7 cell line | [127] |
| Commiphora wightii | Cladosporium sp. | AuNPs | 5–10 | Spherical | Anticancer activity against MCF-7 cell line | [115] |
| Pinus densiflora | Talaromyces purpureogenus | AgNPs | 25 | Round, Triangular | Anticancer activity against A549 cell line | [128] |
Disclaimer/Publisher’s Note: The statements, opinions and data contained in all publications are solely those of the individual author(s) and contributor(s) and not of MDPI and/or the editor(s). MDPI and/or the editor(s) disclaim responsibility for any injury to people or property resulting from any ideas, methods, instructions or products referred to in the content. |
© 2025 by the authors. Licensee MDPI, Basel, Switzerland. This article is an open access article distributed under the terms and conditions of the Creative Commons Attribution (CC BY) license (https://creativecommons.org/licenses/by/4.0/).
Share and Cite
Sawalha, H.; Moulton, S.E.; Winkel, A.; Stiesch, M.; Zaferanloo, B. Role of Endophytic Fungi in the Biosynthesis of Metal Nanoparticles and Their Potential as Nanomedicines. J. Funct. Biomater. 2025, 16, 129. https://doi.org/10.3390/jfb16040129
Sawalha H, Moulton SE, Winkel A, Stiesch M, Zaferanloo B. Role of Endophytic Fungi in the Biosynthesis of Metal Nanoparticles and Their Potential as Nanomedicines. Journal of Functional Biomaterials. 2025; 16(4):129. https://doi.org/10.3390/jfb16040129
Chicago/Turabian StyleSawalha, Hanadi, Simon E. Moulton, Andreas Winkel, Meike Stiesch, and Bita Zaferanloo. 2025. "Role of Endophytic Fungi in the Biosynthesis of Metal Nanoparticles and Their Potential as Nanomedicines" Journal of Functional Biomaterials 16, no. 4: 129. https://doi.org/10.3390/jfb16040129
APA StyleSawalha, H., Moulton, S. E., Winkel, A., Stiesch, M., & Zaferanloo, B. (2025). Role of Endophytic Fungi in the Biosynthesis of Metal Nanoparticles and Their Potential as Nanomedicines. Journal of Functional Biomaterials, 16(4), 129. https://doi.org/10.3390/jfb16040129

